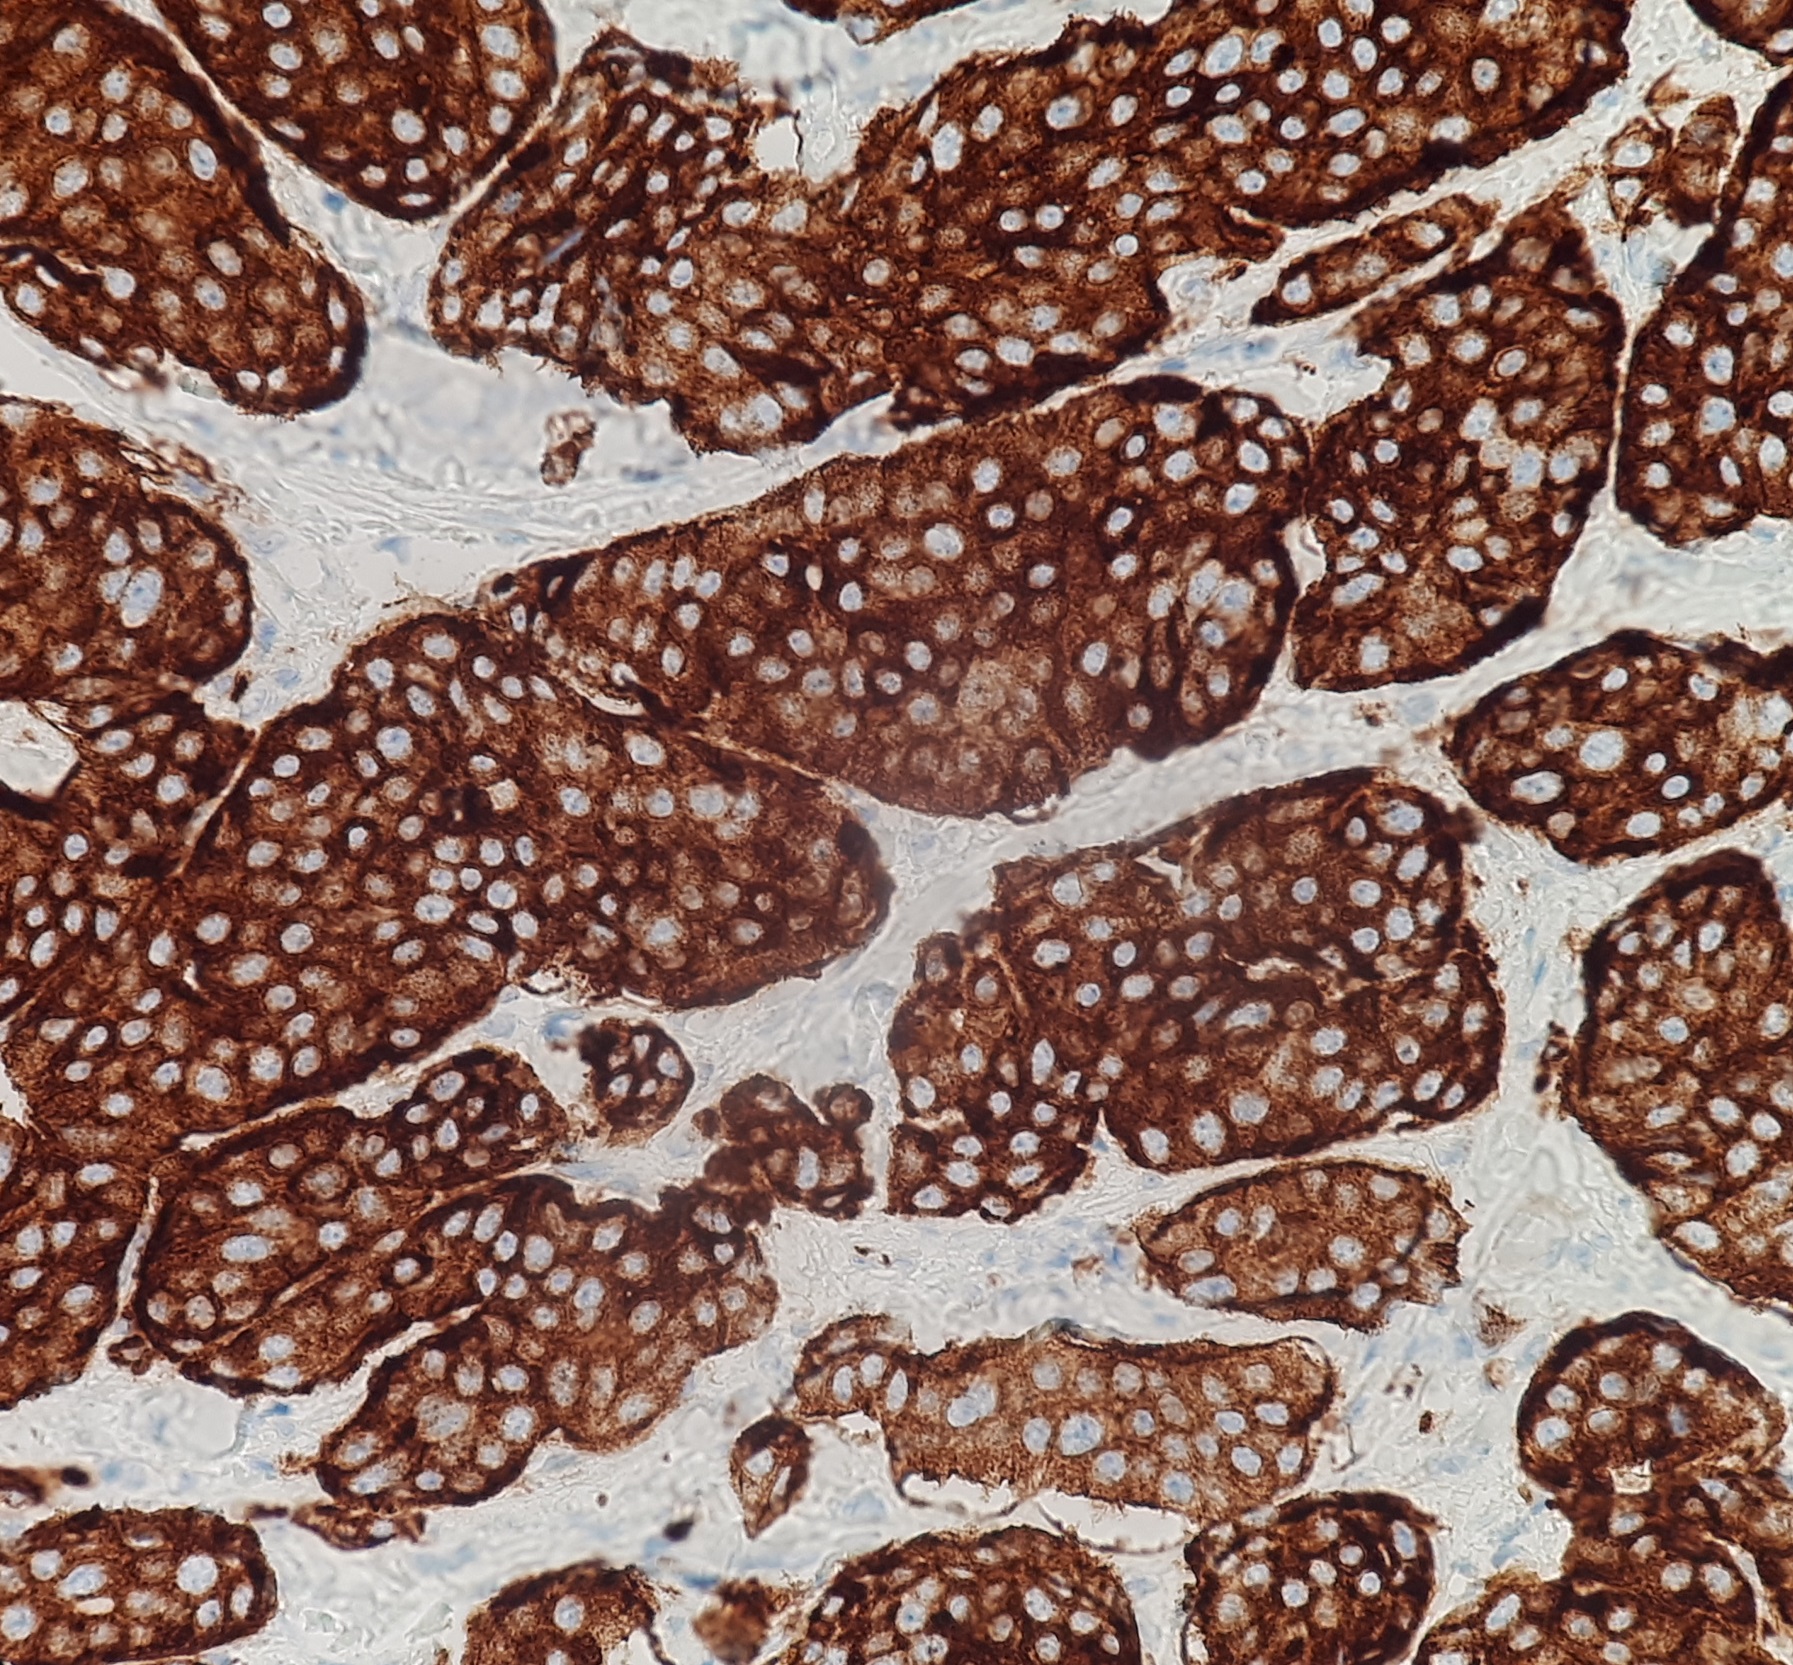

신경내분비 종양
"오늘의AI위키"의 AI를 통해 더욱 풍부하고 폭넓은 지식 경험을 누리세요.
1. 개요
신경내분비 종양은 신경내분비 세포에서 발생하는 다양한 종양을 통칭하며, 성장 속도와 분화도에 따라 분류된다. 역사적으로는 카르시노이드 종양으로 처음 구분되었으며, 세계 보건 기구(WHO)는 종양 등급을 해부학적 기원보다 강조하여 잘 분화된, 잘 분화된 저등급, 분화 불량 고등급의 세 가지 주요 범주로 분류한다. 진단에는 종양 표지자 검사, 영상 검사, 조직 병리학적 검사가 사용되며, 치료는 종양의 위치, 침습성, 호르몬 분비, 전이 여부 등에 따라 수술, 약물 치료, 방사선 치료, 간동맥 색전술 등이 시행된다. 신경내분비 종양의 연간 발생률은 10만 명당 2.5~5명으로 추정되며, 예후는 종양의 특성과 치료 방법에 따라 달라진다.
더 읽어볼만한 페이지
- 췌장암 - 췌장 신경내분비종양
췌장 신경내분비종양(PanNET)은 췌장에서 발생하는 드문 종양으로, 분화도와 공격성에 따라 양성과 악성으로 나뉘며, 생성하는 호르몬에 따라 다양한 유형으로 분류되고, 복통, 요통, 설사, 황달 등의 증상을 유발할 수 있으며, 영상 검사, 호르몬 수치 측정, 생검을 통해 진단하고, 수술, 약물 치료, 표적 치료 등으로 치료하며, 유전적 요인과 관련될 수 있습니다. - 신경내분비학 - 뇌하수체 후엽
뇌하수체 후엽은 시상하부에서 생성된 옥시토신과 바소프레신을 저장하고 분비하는 뇌하수체의 신경부로, 호르몬 생산 세포 없이 축삭과 신경교세포로 구성되어 바소프레신 분비 이상 시 요붕증이나 항이뇨 호르몬 부적절 분비 증후군을 유발할 수 있다. - 신경내분비학 - 방출호르몬
방출 호르몬은 시상하부에서 분비되어 뇌하수체를 자극, 특정 호르몬 분비를 촉진하는 호르몬들을 총칭하며 갑상선자극호르몬 방출호르몬, 부신피질자극호르몬 방출호르몬, 생식샘자극호르몬 분비호르몬, 성장호르몬 방출호르몬 등이 이에 속한다. - 신경계 신생물 - 망막모세포종
망막모세포종은 소아에게 주로 나타나는 악성 종양으로, RB1 또는 MYCN 유전자 돌연변이가 원인이며, 백색동공, 시력 저하, 사시 등의 증상을 보이고, 안구 적출술, 방사선 치료, 화학 요법 등으로 치료하며, 종양 위험도 분류 체계를 통해 관리된다. - 신경계 신생물 - 시신경교종
시신경교종은 시신경 또는 시신경 교차 부위에 생기는 주로 저등급 신경교종 형태의 종양으로, MRI를 통해 종양의 특성을 파악하고 시력 보존을 목표로 수술, 방사선 치료, 항암 화학 요법, 관찰 등으로 치료하며, 종양의 활동성과 침범 여부가 예후에 영향을 미칩니다.
신경내분비 종양 | |
---|---|
일반 정보 | |
![]() | |
분야 | 의학 |
증상 | (정보 없음) |
합병증 | (정보 없음) |
발병 시기 | (정보 없음) |
지속 기간 | (정보 없음) |
유형 | (정보 없음) |
원인 | (정보 없음) |
위험 요인 | (정보 없음) |
진단 | (정보 없음) |
감별 진단 | (정보 없음) |
예방 | (정보 없음) |
치료 | (정보 없음) |
약물 | (정보 없음) |
예후 | (정보 없음) |
빈도 | (정보 없음) |
사망자 | (정보 없음) |
2. 역사
1897년 니콜라이 쿨치츠키는 카르시노이드 종양의 기원이 되는 장크롬친화성 세포를 처음으로 확인했다.[102] 이후 1907년, 독일 뮌헨 대학교의 지크프리트 오버른도르퍼는 소장의 신경내분비 종양을 다른 종양과 처음으로 구별하였다.[112][113][102][103] 그는 이 종양의 느린 성장 속도를 보고, 진정한 암(carcinoma)이라기보다는 "암과 유사하다(carcinoma-like)"는 의미에서 karzinoide|카르치노이데de(Carcinoid|카르시노이드영어)라고 명명했다.[103]
신경내분비 종양은 다양한 기준에 따라 분류된다. 주로 세계 보건 기구(WHO)의 분류 체계에 따라 등급과 세포 분화 정도를 기준으로 나누거나, 종양이 발생한 해부학적 위치에 따라 분류한다. 특히 위장관, 췌장, 폐 등에서 비교적 흔하게 발생하며, 이에 대한 자세한 분류는 하위 문단에서 설명한다.
그러나 1938년에는 이러한 소장 종양 중 일부가 악성일 수 있다는 사실이 밝혀졌다.[102][103] 세로토닌 분비와 관련된 임상적 특징들도 점차 확인되었는데, 1953년에는 세로토닌 분비로 인한 특징적인 "홍조" 현상이 알려졌고,[102] 1952년에는 카르시노이드 심장 질환, 1961년에는 카르시노이드 섬유증이 각각 확인되었다.[102]
신경내분비 종양 세포는 종종 아민 전구체(L-DOPA 및 5-하이드록시트립토판)를 흡수(amine precursor uptake)하고 탈탄산 반응(decarboxylation)을 통해 카테콜아민이나 세로토닌과 같은 생체 아민(amine)을 생성하는 특징을 보인다. 이 때문에 각 과정의 앞 글자를 따서 APUDomas라고 불리기도 했다. 이러한 생화학적 특징은 이 세포들이 모두 발생학적으로 신경 능선에서 기원했을 것이라는 가설로 이어지기도 했으나, 이는 아직 입증되지 않았다.[54][70][104] 신경내분비 세포는 다양한 유형의 호르몬과 아민을 생성할 수 있으며,[104] 다른 호르몬에 반응하는 수용체를 가지기도 한다.
시간이 지남에 따라 신경내분비 종양에 대한 여러 명명법 체계가 등장했으며,[105] 이러한 체계 간의 차이점은 종종 혼란을 야기했다. 특히, 초기에 소장 종양에 국한되었던 '카르시노이드'라는 용어가 췌장 및 폐 등 다른 기관에서 발생한 신경내분비 종양까지 포괄하며 (부정확하게) 사용되기도 했다. 그럼에도 불구하고, 현대의 분류 체계는 공통적으로 분화가 잘 된 종양(저등급 및 중간 등급)과 분화가 불량한 종양(고등급)을 구별한다. 세포의 증식 속도는 종양의 예후를 평가하는 데 중요한 지표로 활용된다.[105] 이처럼 병리학적 분석 기술이 발전함에 따라 신경내분비 종양의 분류 기준은 계속해서 변화해왔다.
3. 분류
3. 1. WHO 분류
세계 보건 기구(WHO) 분류 체계는 신경내분비 종양(NET)을 종양 등급을 해부학적 기원보다 강조하여 세 가지 주요 범주로 나눈다.[105][57]
또한, WHO 체계는 술잔 세포 암종처럼 신경내분비 특징과 상피 암종 특징을 모두 가진 혼합 종양도 인정한다. 술잔 세포 암종은 드문 위장관 종양이다.[4]
특정 종양을 이 범주들 중 하나로 분류하는 것은 명확하게 정의된 조직학적 특징에 따라 결정된다. 이러한 특징에는 종양 크기, 림프혈관 침윤 여부, 분열 수, Ki-67 표지 지수, 인접 장기 침범 여부, 전이 유무, 호르몬 생성 여부 등이 포함된다.[105][57]
WHO의 2022년 종양 등급 분류는 대부분의 NET, 특히 위장관 또는 췌담관 NET, 상부 호흡소화기 NET, 타액선 NET에 대해 3단계 등급 시스템을 권장한다. 이 시스템은 분열 속도와 Ki-67 지수로 평가된 증식 정도를 기준으로 NET를 1등급(G1, 저등급), 2등급(G2, 중간 등급), 3등급(G3, 고등급)으로 분류한다. 종양 괴사는 예후가 더 나쁠 가능성을 시사하는 요인으로 인식되지만, 위장관 또는 췌담관 NET의 등급 분류에는 포함되지 않는다. 그러나 종양 괴사의 유무는 상부 호흡소화기, 폐, 흉선 등 다른 여러 부위에서 발생하는 NET의 등급 분류 요소이다.[5]
신경내분비 암종은 정의상 분화가 잘 안 된 고등급 신경내분비 신생물이므로, 별도의 종양 등급 지정은 불필요하다.[5] 폐 및 흉선 신경내분비 신생물은 전형적 및 비전형적 유암종, 소세포 암종, 대세포 신경내분비 암종을 포함하여 유사한 방식으로 분류된다.[5]
더불어, 2022년 WHO 분류는 수질 갑상선 암종에 대해 분열 수, Ki-67 지수, 종양 괴사 유무를 기반으로 하는 2단계 등급 시스템을 도입했다. 여기서 사용되는 기준값은 위장관, 호흡소화기, 폐 기원 종양의 기준값과는 다르다는 점에 유의해야 한다.[5]
3. 2. 해부학적 분포
전통적으로 신경내분비 종양은 기원하는 해부학적 위치에 따라 분류되어 왔다. 신경내분비 종양은 신체의 여러 부위에서 발생할 수 있으며, 가장 흔하게는 창자, 췌장 또는 폐에서 발생한다. 신경내분비 종양을 유발할 수 있는 다양한 종류의 세포는 내분비선에 존재하며, 신체 전체에 널리 분포되어 있다. 특히 위장관 및 폐 시스템에서 상대적으로 더 흔한 쿨치츠키 세포 또는 유사한 장크롬친화성 유사 세포에서 기원하는 경우가 많다.[6]
신경내분비 종양에는 위장관과 췌장의 섬세포의 특정 종양,[1] 특정 흉선 및 폐 종양, 그리고 갑상선의 수질 암종이 포함된다.[1] 뇌하수체, 부갑상선, 그리고 부신수질의 세포 특성이 유사한 종양은 때때로 포함되거나[7] 제외되기도 한다.[1]
신경내분비 종양의 광범위한 범주 내에는 다양한 종양 유형이 있으며,[8] 이는 해당 조직에서 발생하는 종양 또는 암의 작은 비율만을 차지한다. 주요 발생 부위 및 관련 종양 유형은 다음과 같다.
또한, 다음과 같은 유전 질환과 관련하여 신경내분비 종양이 발생할 수 있다.[30]
신경내분비 종양은 이처럼 전신에서 발생할 수 있지만, 특히 식도, 위, 십이지장, 소장, 충수, 직장 등의 소화관, 췌장과 폐 등에서 호발한다. 그 외 뇌하수체, 자궁, 담낭 등에서도 보고된 바 있다.
위와 장의 "소화관"과 "췌장"에 발생하는 종양에 대해서는 과거 "카르시노이드"라는 명칭이 사용되었으나, 최근에는 세계 보건 기구(WHO) 산하 국제 암 연구 기관(IARC)의 분류에 따라 "신경내분비 종양"으로 표기하는 추세이다. WHO 분류는 다음과 같이 변화해왔다.
1980 WHO 분류 | 2000/2004 WHO 분류 (소화관/췌장) | 2010 WHO 분류 (소화관/췌장) |
---|---|---|
카르시노이드 | 분화도가 좋은 내분비 종양 분화도가 좋은 내분비 암종 분화도가 나쁜 내분비 암종/소세포 암종 | 신경내분비 종양 Grade 1 유사 분열 수 <2/ 10HPF Ki67 지수 ≤2% 신경내분비 종양 Grade 2 유사 분열 수 2-20/ 10HPF Ki67 지수 3-20% 신경내분비 암종 유사 분열 수 >20/ 10HPF Ki67 지수 >20% |
점액 카르시노이드 혼합 형태 카르시노이드-선암종 | 혼합 외분비-내분비 암종 | 혼합 선 신경내분비 암종 |
가성 종양 병변 | 종양 유사 병변 | 과형성 및 전암성 병변 |
폐의 신경내분비 종양은 "폐암" 분류의 하나로 기재되며, 2015년 WHO 분류에서는 "폐 소세포암"과 "카르시노이드 종양"이 "신경내분비 종양"으로 통합되었다.
2004 WHO 분류 (폐) | 2015 WHO 분류 (폐) |
---|---|
선암종 편평 세포 암종 소세포암 카르시노이드 종양 *전형적 카르시노이드 종양 *비정형 카르시노이드 종양 대세포암 선 편평 세포 암종 육종양 암종 기타. | 선암종 편평 세포 암종 신경내분비 종양 *소세포암 혼합 소세포암 *대세포 신경내분비 암종 혼합 대세포 신경내분비 암종 *카르시노이드 종양 전형적 카르시노이드 종양 비정형 카르시노이드 종양 *전구 병변 미만성 특발성 폐 신경내분비 세포 증식증 대세포암 선 편평 세포 암종 육종양 암종 기타. |
3. 3. 소화관·췌장
신경내분비 종양은 전통적으로 발생한 해부학적 위치에 따라 분류되어 왔으며, 창자, 췌장, 폐 등 신체 여러 부위에서 발생할 수 있다.[6] 특히 위, 십이지장, 소장, 충수, 직장 등 소화관과 췌장에서 자주 발견된다. 이러한 종양을 유발하는 세포는 내분비선에 존재하며, 특히 위장관계에 흔한 쿨치츠키 세포나 유사한 장크롬친화성 유사 세포 등이 있다.[6]소화관 및 췌장의 신경내분비 종양은 위장 췌장 신경내분비 종양(GEP-NET, GastroEnteroPancreatic NeuroEndocrine Tumor)으로 통칭된다.[14][15] GEP-NET은 발생 위치에 따라 다음과 같이 분류될 수 있다.
- 전장 GEP-NET: 위, 근위부 십이지장, 췌장의 신경내분비 종양을 포함한다. 넓게는 흉선, 폐, 기관지까지 포함하기도 한다.
- 췌장 내분비 종양은 별도로 분류되기도 한다.[16]
- 중장 GEP-NET: 십이지장 원위부 절반부터 횡행결장 근위부 2/3까지 발생한다.
- 충수에서 발생하는 경우, 분화도에 따라 양성, 악성 가능성 불확실, 낮은 악성 가능성의 신경내분비 종양 및 암종, 혼합 외분비-신경내분비 암종(술잔 세포 암종 등)으로 나뉜다.[17]
- 후장 GEP-NET: 횡행결장 원위부 1/3부터 직장까지 발생한다.[18][19]
과거 소화관과 췌장의 신경내분비 종양을 지칭하던 '카르시노이드'라는 명칭은 세계 보건 기구(WHO) 산하 국제 암 연구 기관(IARC)의 분류 개정에 따라 점차 '신경내분비 종양(NET)'으로 대체되었다. 분류 체계는 다음과 같이 변화해왔다.
1980 WHO 분류 | 2000/2004 WHO 분류 | 2010 WHO 분류 |
---|---|---|
카르시노이드 | 분화도가 좋은 내분비 종양 분화도가 좋은 내분비 암종 분화도가 나쁜 내분비 암종/소세포 암종 | 신경내분비 종양 Grade 1 유사 분열 수 <2/ 10HPF Ki67 지수 ≤2% 신경내분비 종양 Grade 2 유사 분열 수 2-20/ 10HPF Ki67 지수 3-20% 신경내분비 암종 유사 분열 수 >20/ 10HPF Ki67 지수 >20% |
점액 카르시노이드 혼합 형태 카르시노이드-선암종 | 혼합 외분비-내분비 암종 | 혼합 선 신경내분비 암종 |
가성 종양 병변 | 종양 유사 병변 | 과형성 및 전암성 병변 |
3. 4. 폐
신경내분비 종양은 폐에서도 발생할 수 있다.[6] 폐 신경내분비 종양은 다음과 같은 종류를 포함한다.[11][12]- 기관지[10]
- 폐 카르시노이드 종양: 전형적 카르시노이드(TC; 낮은 등급), 비정형 카르시노이드(AC; 중간 등급)
- 소세포 폐암 (SCLC)
- 폐의 대세포 신경내분비 암종 (LCNEC)[13]
폐암 분류에서 신경내분비 종양의 위치는 시간이 지남에 따라 변해왔다. 특히 세계보건기구(WHO)의 2015년 분류에서는 이전 분류와 달리 "소세포 폐암"과 "카르시노이드 종양"을 "신경내분비 종양"이라는 하나의 큰 범주로 통합하였다. 이는 2004년 분류에서 이들이 별개의 항목으로 취급되었던 것과 대조된다.
다음은 2004년과 2015년 WHO 폐암 분류의 주요 차이점을 보여주는 표이다.
2004 WHO 분류 | 2015 WHO 분류 |
---|---|
선암종 편평 세포 암종 소세포암 카르시노이드 종양 *전형적 카르시노이드 종양 *비정형 카르시노이드 종양 대세포암 선 편평 세포 암종 육종양 암종 기타. | 선암종 편평 세포 암종 신경내분비 종양 *소세포암 혼합 소세포암 *대세포 신경내분비 암종 혼합 대세포 신경내분비 암종 *카르시노이드 종양 전형적 카르시노이드 종양 비정형 카르시노이드 종양 *전구 병변 미만성 특발성 폐 신경내분비 세포 증식증 대세포암 선 편평 세포 암종 육종양 암종 기타. |
4. 임상 양상
신경내분비 종양의 임상 양상은 종양의 위치, 크기, 분비하는 호르몬의 종류와 양에 따라 매우 다양하게 나타난다. 상당수의 신경내분비 종양은 특별한 증상을 유발하지 않아 건강 검진이나 다른 이유로 인한 검사 중에 우연히 발견되기도 한다.[45][103]
증상이 나타나는 경우, 이는 종양이 분비하는 호르몬으로 인한 것일 수도 있고, 종양 자체의 크기나 위치로 인한 것일 수도 있다. 예를 들어, 소장 등 위장관에서 발생하는 유암종 중 일부는 세로토닌과 같은 호르몬을 과도하게 분비하여 홍조, 설사, 천식과 유사한 호흡 곤란 등의 증상을 특징으로 하는 유암종 증후군을 일으킬 수 있다.[46][47] 드물지만, 호르몬이 급격하게 분비되어 심각한 증상을 유발하는 유암종 위기가 발생하기도 한다.[1] 또한, 만성적인 호르몬 과다 분비는 심장 판막 문제나 영양 결핍(펠라그라)으로 이어질 수도 있다.[47][1]
췌장 신경내분비 종양(PanNET) 역시 호르몬 분비 여부에 따라 증상이 달라진다. 특정 호르몬을 분비하여 저혈당, 위궤양 등 다양한 증상을 유발하는 기능성 종양과, 호르몬을 분비하지 않거나 임상적으로 의미 없는 물질을 분비하여 증상이 없는 비기능성 종양으로 나뉜다.[30] 비기능성 종양은 크기가 커지면서 복통이나 황달 등의 증상을 유발할 수 있다.
위장관이나 췌장 외에 폐, 흉선 등 다른 부위에서도 신경내분비 종양이 발생할 수 있다. 폐에 생긴 종양은 기침, 객혈, 호흡 곤란 등 호흡기 증상을 유발하거나, 쿠싱 증후군과 같은 전신 증상을 동반하기도 한다. 일부 신경내분비 종양은 성장 호르몬이나 코르티솔과 같은 다른 호르몬을 분비하여 거인증이나 쿠싱 증후군과 유사한 증상을 나타내기도 한다.[48] 때로는 종양으로 인한 출혈이나 장 폐쇄가 첫 증상으로 나타나기도 한다.[89]
4. 1. 위장관 신경내분비 종양 (GEP-NET)
개념적으로, 위장관 신경내분비 종양(GEP-NET) 범주 내에는 크게 두 가지 유형의 신경내분비 종양(NET)이 있다. 하나는 위장관(GI) 계통에서 발생하는 것이고 다른 하나는 췌장에서 발생하는 것이다. 사용상, "카르시노이드"라는 용어는 종종 이 두 가지 모두에 적용되었지만, 때로는 위장관 기원의 NET(여기에서처럼) 또는 임상 증상과 관련된 기능적 호르몬 또는 폴리펩타이드를 분비하는 종양에 한정적으로 적용되기도 한다.유암종은 가장 흔하게 소장, 특히 회장에 영향을 미치며, 충수의 가장 흔한 악성 종양이다. 많은 유암종은 증상이 없으며, 관련 없는 이유로 수술을 받을 때 발견된다. 이러한 우연히 발견되는 유암종은 흔하며, 한 연구에 따르면 10명 중 1명이 유암종을 가지고 있다고 한다.[45] 많은 종양은 다른 곳으로 전이된 경우에도 증상을 일으키지 않는다.[103] 반면, 다른 종양은 매우 작더라도 호르몬을 분비하여 부작용을 일으킬 수 있다.[89]
유암종의 10% 미만[46], 주로 일부 중간 창자 유암종은 다양한 호르몬, 특히 세로토닌(5-HT) 또는 물질 P를 과도하게 분비하여[47] 유암종 증후군이라고 불리는 증상의 집합을 유발한다.
많은 양의 호르몬이 급성으로 분비되면 급격한 홍조, 기관지 경련, 빈맥, 넓고 빠르게 변동하는 혈압을 동반하는 유암종 위기[1]가 발생할 수 있다. 이는 때때로 식단,[47] 알코올,[47] 수술,[1][47] 화학 요법,[47] 색전술 또는 고주파 절제술과 같은 요인에 의해 유발된다.[1]
만성적으로 높은 수준의 세로토닌에 노출되면 심장 판막, 특히 삼첨판과 폐동맥판이 두꺼워지고, 장기간에 걸쳐 울혈성 심부전으로 이어질 수 있다.[47] 그러나 판막 치환술이 필요한 경우는 드물다.[84] 세로토닌의 과도한 유출은 트립토판 고갈을 유발하여 나이아신 결핍, 따라서 펠라그라로 이어질 수 있다.[1] 이는 피부염, 치매, 설사와 관련이 있다. 이러한 종양 중 일부는 다른 많은 호르몬을 분비할 수 있으며, 가장 흔하게 거인증을 유발할 수 있는 성장 호르몬 또는 쿠싱 증후군을 유발할 수 있는 코르티솔이다.[48]
때때로, 출혈 또는 종양 덩어리의 영향이 나타나는 증상이다. 장 폐쇄가 발생할 수 있으며, 이는 때때로 종양 부위의 심한 섬유모세포 반응 또는 장간막의 섬유증 효과로 인한 신경내분비 종양(NET) 분비물의 영향일 수 있다.[89]
췌장 신경내분비 종양(PanNET)은 흔히 "섬세포 종양"[53][49] 또는 "췌장 내분비 종양"[105]이라고 불린다. PanNET 명칭은 현재 세계 보건 기구(WHO) 지침에 따른 것이다. 역사적으로 PanNET은 다양한 용어로 불려 왔으며, 여전히 "섬세포 종양" 또는 "췌장 내분비 종양"이라고 불린다.[105] PanNET은 췌장 내에서 발생한다. 이는 외분비 췌장에서 발생하는 일반적인 형태의 췌장암인 선암종과는 매우 다르다. 췌장 종양의 약 95%가 선암종이며, 임상적으로 유의미한 췌장 신생물의 1~2%만이 GEP-NET이다.
분화가 잘되거나 중간 정도인 PanNET은 때때로 섬세포 종양이라고 불리며, 신경내분비암(NEC)(섬세포 암종과 동의어)은 더 공격적이다. PanNET의 최대 60%는 비분비성이거나 비기능성이며, 췌장 폴리펩타이드(PPoma), 크로모그라닌 A, 뉴로텐신과 같은 물질을 분비하지 않거나, 분비하더라도 그 양이나 유형이 임상 증후군을 유발하지 않는다. 다만 혈중 수치는 상승할 수 있다.[30] 기능성 종양은 해당 주요 기사에서 논의된 바와 같이, 췌장 신경내분비 종양에서 가장 강력하게 분비되는 호르몬에 따라 분류되는 경우가 많다.
신경내분비 종양은 전신에서 발생할 수 있다. 다만, 식도, 위, 십이지장, 소장, 충수, 직장 등의 소화관, 췌장과 폐 등에서 주로 발생한다. 또한, 뇌하수체, 자궁, 담낭 등에서도 보고된 바 있다.
4. 2. 기타 신경내분비 종양
위장관계 및 췌장에서 발생하는 주요 신경내분비 종양(GEP-NET) 외에도, 폐, 흉선, 부갑상선 등 신체 여러 부위에서 드물게 신경내분비 종양이 발생할 수 있다.
특히 기관지에서 발생하는 카르시노이드 종양은 기도를 막거나 폐렴, 흉막염, 호흡 곤란, 기침, 객혈 등을 유발할 수 있다. 또한 쇠약감, 메스꺼움, 체중 감소, 야간 발한, 신경통, 쿠싱 증후군과 같은 전신 증상을 동반하기도 하지만, 아무런 증상이 없는 경우도 있다.
동물에게서도 신경내분비 종양이 발생하는데, 개의 간에서 발생하는 신경내분비암이나 태즈메이니아 데빌에게 발생하는 데빌 얼굴 종양 질환 등이 보고된 바 있다.[50][51][52]
5. 진단
신경내분비 종양의 진단을 위해서는 다양한 검사 방법이 활용된다. 혈액이나 소변 검사를 통해 특정 종양 표지자(예: 크로모그라닌 A) 수치를 확인하거나, CT, MRI, PET-CT, 소마토스타틴 수용체 스캔신티그래피와 같은 영상 검사를 통해 종양의 위치, 크기, 전이 여부 등을 평가한다. 정확한 진단과 병기 설정을 위해 조직을 직접 채취하여 현미경으로 관찰하는 생검이 필요한 경우도 있다.
5. 1. 종양 표지자
신경내분비 종양(NET)이 분비하는 호르몬으로 인해 증상이 나타나는 경우, 해당 호르몬의 혈중 농도나 관련 소변 생성물을 측정하여 초기 진단 또는 종양의 변화를 평가하는 데 활용할 수 있다. 그러나 종양 세포의 실제 분비 활성과 특정 호르몬에 대한 조직의 면역 반응성은 때때로 다를 수 있다.[66]
NET은 다양한 물질을 분비할 수 있어 잠재적인 표지자는 많지만, 실제 임상에서는 제한된 종류의 표지자만으로도 충분한 경우가 많다.[1] 종양이 분비하는 특정 호르몬 외에, 진단 및 추적 관찰에 중요하게 사용되는 종양 표지자는 다음과 같다.
표지자 | 설명 |
---|---|
크로모그라닌 A (CgA) | 신경내분비 세포에서 분비되는 단백질로, 특히 전이성 카르시노이드 종양의 99%에서 발견될 정도로 중요한 표지자이다.[55] |
소변 5-히드록시인돌아세트산 (5-HIAA) | 세로토닌의 주요 대사 산물로, 카르시노이드 증후군 진단에 유용하다. |
신경 특이적 에놀라제 (NSE) | 신경 세포 및 신경내분비 세포에 존재하는 효소(감마-감마 이량체)로, 특정 NET의 표지자로 사용될 수 있다. |
시냅토피신 (P38) | 신경 전달 물질을 포함하는 소포의 막 단백질로, 면역조직화학 염색을 통해 NET 진단에 널리 활용된다. |
최근 연구를 통해 새로운 표지자들도 주목받고 있다. 예를 들어, N-말단이 잘린 Hsp70 변이체는 정상적인 췌장 섬 세포에는 없지만 NET 세포에는 존재하는 것으로 밝혀졌다.[56] 또한, 장의 발달과 분화에 필수적인 홈박스 유전자 산물인 CDX2는 장 NET에서 높은 수치로 관찰된다. 크로모그라닌 계열의 구성원인 신경내분비 분비 단백질-55는 췌장 내분비 종양에서는 관찰되지만 장 NET에서는 관찰되지 않아 감별 진단에 도움을 줄 수 있다.[56]
5. 2. 영상 검사
신경내분비 종양을 진단하고 평가하기 위해 다양한 영상 검사가 사용된다.형태학적 영상 검사로는 CT 스캔, MRI, 초음파 검사, 내시경 검사(내시경 초음파 포함)가 일반적으로 활용된다. 특히 다단계 CT와 MRI는 진단뿐만 아니라 치료 경과를 평가하는 데에도 널리 쓰인다. 다단계 CT는 요오드 기반 조영제를 정맥 주사하기 전과 후, 그리고 후기 동맥상과 문맥상에서 촬영하는 방식(3단계 연구)으로 진행하는 것이 일반적이다. MRI가 원발 종양 발견과 전이 평가에서 CT보다 우수한 경우가 많지만, 실제 임상 현장에서는 CT, 특히 조영 증강 CT(CECT)가 더 널리 사용되는 경향이 있다. 따라서 다단계 CT가 종종 우선적으로 선택되는 검사법이다.[57][58]
핵의학 영상, 또는 분자 영상 기술의 발전은 신경내분비 종양 환자의 진단과 치료 방식을 개선하는 데 크게 기여했다. 이 기술은 단순히 질병의 위치를 찾는 것을 넘어 종양의 특성까지 파악할 수 있게 해주기 때문이다. 신경내분비 종양 세포 표면에는 소마토스타틴 수용체가 많이 발현되어 있는데, 이는 영상 검사에서 중요한 표적이 된다. 옥트레오티드는 체내 소마토스타틴의 반감기를 늘린 합성 유사체이다. 이를 이용한 검사가 바로 소마토스타틴 수용체 스캔신티그래피(SRS 또는 SSRS), 일명 옥트레오스캔이다. 이 검사에서는 방사성 동위원소(인듐-111 등)와 결합된 옥트레오티드를 정맥으로 주사하여, 옥트레오티드에 대한 친화성이 높은 종양 세포가 있는 비교적 큰 병변을 찾아낸다.
최근에는 소마토스타틴 수용체 영상 검사를 양전자 방출 단층 촬영(PET) 기술로 수행하는 경우가 늘고 있다. PET는 더 높은 해상도의 3차원 영상을 더 빠르게 얻을 수 있다는 장점이 있다. 특히 갈륨-68(68Ga)을 이용한 수용체 PET-CT는 기존의 옥트레오스캔보다 훨씬 정확한 것으로 알려져 있다.[59] 이 때문에 신경내분비 종양에 대한 옥트레오스캔은 점차 갈륨-68 DOTATOC PET-CT 스캔으로 대체되는 추세이다.[60]
불소-18 플루오로데옥시글루코스(18F-FDG)를 이용한 PET 영상 검사(FDG-PET) 역시 일부 신경내분비 종양을 영상화하는 데 유용할 수 있다.[61] 이 검사는 방사성 포도당(FDG)을 정맥 주사하여 시행하는데, 빠르게 성장하는 종양일수록 더 많은 포도당을 소모하는 원리를 이용한다. 따라서 FDG-PET는 종양의 성장 속도, 즉 공격성을 평가하는 데 도움을 줄 수 있다. 하지만 신경내분비 종양은 대체로 천천히 자라고 분화도가 좋은 경우가 많아, FDG-PET에서는 잘 나타나지 않을 수도 있다.
갈륨 표지 소마토스타틴 유사체 PET와 18F-FDG PET와 같은 기능적 영상 검사를 함께 활용하면 신경내분비 종양의 병기를 더 정확하게 설정하고 예후를 예측하는 데 도움이 된다.[62] 이 두 검사를 결합하면 각각 종양 세포 표면의 소마토스타틴 수용체(SSTR) 발현 정도와 해당 종양의 대사 활성도를 정량적으로 평가할 수 있다.[61] 이는 전신적인 정보를 제공함으로써, 특정 부위에서 얻은 조직 검사 결과만으로는 알기 어려운 종양의 전체적인 특성을 파악하고, 개별 환자에게 가장 적합한 치료법을 선택하는 데 중요한 정보를 제공한다.[63]
신경내분비 종양 진단 및 평가에 활용될 수 있는 주요 검사는 다음과 같다.
검사 종류 | 주요 내용 및 특징 |
---|---|
종양 표지자 검사 | 혈액 검사 등을 통해 특정 표지자 수치 확인 (예: 크로모그래닌 A) |
CT | 형태학적 영상 진단, 특히 다단계 CT가 널리 사용됨 |
MRI | CT보다 원발 종양 및 전이 발견에 우수할 수 있음 |
PET-CT | 기능적 영상 진단. 갈륨-68 DOTATATE/DOTATOC PET-CT (소마토스타틴 수용체 영상), FDG-PET (종양 대사 활성도 평가) 등 |
소마토스타틴 수용체 신티그래피 | 옥트레오티드를 이용한 핵의학 검사 (옥트레오스캔). 갈륨-68 PET-CT로 대체되는 추세 |
생검 | 조직 검사를 통해 확진 |
5. 3. 조직 병리학
신경내분비 병변은 세포의 모양보다는 세포가 얼마나 빨리 자라는지를 나타내는 표지에 따라 조직학적으로 등급이 매겨진다. 현재 세계 보건 기구(WHO)는 모든 위장관 및 췌장 신경내분비 종양에 대해 다음과 같은 등급 분류 체계를 권장한다.[36]
등급 | 유사분열 수 (10 HPF당) | Ki-67 지수 (%) |
---|---|---|
GX | 등급을 평가할 수 없음 | |
G1 | < 2 | < 3% |
G2 | 2 ~ 20 | 3~20% |
G3 | > 20 | > 20% |
유사분열 수와 Ki-67 지수가 서로 다른 등급을 가리킬 경우, 더 높은 등급을 부여하는 수치를 기준으로 삼는다.
G1 및 G2 등급은 신경내분비 종양(NET, Neuroendocrine Tumor)으로 분류되며, 이전에는 유암종(카르시노이드)이라고 불렸다. G3 등급은 신경내분비 암종(NEC, Neuroendocrine Carcinoma)으로 분류된다.
최근에는 G3 범주를 예후(치료 후 경과 예측)를 더 잘 반영하기 위해, 조직학적으로 분화가 잘 된 종양과 분화가 잘 안된 종양으로 더 세분화하자는 제안이 있다.[37]
진단을 위해 다음과 같은 검사가 시행될 수 있다.
- 종양 표지자: 크로모그래닌 A(Chromogranin A)가 특히 유용하다.
- CT
- MRI
- PET-CT
- 소마토스타틴 수용체 신티그래피(Somatostatin receptor scintigraphy)
- 생검


병리 진단 시에는 우선 현미경으로 세포 형태의 이상 유무를 관찰한다. 또한, 특정 단백질에 반응하는 항체를 이용하여 종양 세포를 식별하는 면역 염색(Immunostaining) 방법을 사용하기도 한다.[106] 면역 염색은 특정 단백질의 존재 유무를 색깔로 나타내어 현미경 관찰을 용이하게 한다.[107] 신경내분비 종양의 병리 진단에 사용될 수 있는 면역 염색 표지자의 예는 다음과 같다.
6. 병기 설정
현재 모든 신경내분비 종양에 대한 단일 병기 설정 시스템은 없다. 일반적으로 분화가 잘 된 병변은 해부학적 위치에 따라 자체 병기 설정 시스템을 가지고 있는 반면, 분화가 불량하거나 혼합된 병변은 해당 위치의 암으로 병기가 설정된다. 예를 들어, 위 신경내분비암(NEC) 및 혼합 선-신경내분비 암은 위의 원발성 암으로 병기가 설정된다.[38]
위장관 췌장 Grade 1 및 Grade 2 신경내분비 종양의 TNM 병기는 다음과 같다.
원발성 종양 (T) | |
---|---|
T 범주 | 종양 기준 |
TX | 원발성 종양을 평가할 수 없음 |
T0 | 원발성 종양의 증거 없음 |
T1 | 고유층 또는 점막하층을 침범하고 크기가 1cm 이하 |
T2 | 근육층을 침범하거나 크기가 1cm 초과 |
T3 | 근육층을 관통하여 상부 장막의 관통 없이 장막하 조직으로 침범 |
T4 | 내장 복막(장막) 또는 다른 장기 또는 인접 구조물을 침범 |
국소 림프절 (N) | |
N 범주 | N 기준 |
NX | 국소 림프절을 평가할 수 없음 |
N0 | 국소 림프절 전이 없음 |
N1 | 국소 림프절 전이 |
원격 전이 (M) | |
M 범주 | M 기준 |
M0 | 원격 전이 없음 |
M1 | 원격 전이 |
M1a | 간에 국한된 전이 |
M1b | 적어도 하나의 간외 부위에 전이 |
M1c | 간 및 간외 전이 모두 존재 |
AJCC 예후 병기 그룹 | |
병기 | 기준 |
I | T1, N0, M0 |
II | T2 또는 T3, N0, M0 |
III | 모든 T, N1, M0; T4, N0, M0 |
IV | 모든 T, 모든 N, M1 |
원발성 종양 (T) | |
---|---|
T 범주 | 종양 기준 |
TX | 원발성 종양을 평가할 수 없음 |
T1 | 점막 또는 점막하층만 침범하고 크기가 1cm 이하 (십이지장 종양) 오디 괄약근 내에 국한되고 크기가 1cm 이하 (팽대부 종양) |
T2 | 근육층을 침범하거나 1cm 초과 (십이지장) 괄약근을 관통하여 십이지장 점막하층 또는 근육층을 침범하거나 1cm 초과 (팽대부) |
T3 | 췌장 또는 췌장 주위 지방 조직을 침범 |
T4 | 내장 복막(장막) 또는 다른 장기를 침범 |
국소 림프절 (N) | |
N 범주 | N 기준 |
NX | 국소 림프절을 평가할 수 없음 |
N0 | 국소 림프절 전이 없음 |
N1 | 국소 림프절 전이 |
원격 전이 (M) | |
M 범주 | M 기준 |
M0 | 원격 전이 없음 |
M1 | 원격 전이 |
M1a | 간에 국한된 전이 |
M1b | 적어도 하나의 간외 부위에 전이 |
M1c | 간 및 간외 전이 모두 존재 |
AJCC 예후 병기 그룹 | |
병기 | 기준 |
I | T1, N0, M0 |
II | T2 또는 T3, N0, M0 |
III | T4, N0, M0; 모든 T, N1, M0 |
IV | 모든 T, 모든 N, M1 |
원발성 종양 (T) | |
---|---|
T 범주 | 종양 기준 |
TX | 원발성 종양을 평가할 수 없음 |
T0 | 원발성 종양의 증거 없음 |
T1 | 고유층 또는 점막하층을 침범하고 크기가 1cm 이하 |
T2 | 근육층을 침범하거나 크기가 1cm 초과 |
T3 | 근육층을 관통하여 상부 장막의 관통 없이 장막하 조직으로 침범 |
T4 | 내장 복막(장막) 또는 다른 장기 또는 인접 구조물을 침범 |
국소 림프절 (N) | |
N 범주 | N 기준 |
NX | 국소 림프절을 평가할 수 없음 |
N0 | 국소 림프절 전이 없음 |
N1 | 12개 이하의 림프절 전이 |
N2 | 큰 장간막 덩어리 (> 2cm) 및 / 또는 광범위한 림프절 침착 (12개 이상), 특히 상장간막 혈관을 둘러싸는 경우 |
원격 전이 (M) | |
M 범주 | M 기준 |
M0 | 원격 전이 없음 |
M1 | 원격 전이 |
M1a | 간에 국한된 전이 |
M1b | 적어도 하나의 간외 부위에 전이 |
M1c | 간 및 간외 전이 모두 존재 |
AJCC 예후 병기 그룹 | |
병기 | 기준 |
I | T1, N0, M0 |
II | T2 또는 T3, N0, M0 |
III | 모든 T, N1 또는 N2, M0; T4, N0, M0; |
IV | 모든 T, 모든 N, M1 |
원발성 종양 (T) | |
---|---|
T 범주 | 종양 기준 |
TX | 원발성 종양을 평가할 수 없음 |
T0 | 원발성 종양의 증거 없음 |
T1 | 최대 크기가 2cm 이하 |
T2 | 종양이 2cm 초과 4cm 이하 |
T3 | 종양이 4cm 초과 또는 장막하 침범 또는 장간막 침범 |
T4 | 복막을 천공하거나 다른 장기 또는 구조물을 직접 침범 (인접한 장의 인접한 장막하층으로의 직접적인 벽 확장 제외) |
국소 림프절 (N) | |
N 범주 | N 기준 |
NX | 국소 림프절을 평가할 수 없음 |
N0 | 국소 림프절 전이 없음 |
N1 | 국소 림프절 전이 |
원격 전이 (M) | |
M 범주 | M 기준 |
M0 | 원격 전이 없음 |
M1 | 원격 전이 |
M1a | 간에 국한된 전이 |
M1b | 적어도 하나의 간외 부위에 전이 |
M1c | 간 및 간외 전이 모두 존재 |
AJCC 예후 병기 그룹 | |
병기 | 기준 |
I | T1, N0, M0 |
II | T2 또는 T3, N0, M0 |
III | 모든 T, N1, M0; T4, N1, M0 |
IV | 모든 T, 모든 N, M1 |
원발성 종양 (T) | |
---|---|
T 범주 | 종양 기준 |
TX | 원발성 종양을 평가할 수 없음 |
T0 | 원발성 종양의 증거 없음 |
T1 | 고유층 또는 점막하층을 침범하고 크기가 2cm 이하 |
T1a | 최대 크기가 1cm 미만 |
T1b | 최대 크기가 1cm–2cm |
T2 | 근육층을 침범하거나 크기가 2cm 초과하고 고유층 또는 점막하층 침범 |
T3 | 근육층을 관통하여 상부 장막의 관통 없이 장막하 조직으로 침범 |
T4 | 내장 복막(장막) 또는 다른 장기 또는 인접 구조물을 침범 |
국소 림프절 (N) | |
N 범주 | N 기준 |
NX | 국소 림프절을 평가할 수 없음 |
N0 | 국소 림프절 전이 없음 |
N1 | 국소 림프절 전이 |
원격 전이 (M) | |
M 범주 | M 기준 |
M0 | 원격 전이 없음 |
M1 | 원격 전이 |
M1a | 간에 국한된 전이 |
M1b | 적어도 하나의 간외 부위에 전이 |
M1c | 간 및 간외 전이 모두 존재 |
AJCC 예후 병기 그룹 | |
병기 | 기준 |
I | T1, N0, M0 |
IIA | T2, N0, M0 |
IIB | T3, N0, M0 |
IIIA | T4, N0, M0 |
IIIB | 모든 T, N1, M0 |
IV | 모든 T, 모든 N, M1 |
원발성 종양 (T) | |
---|---|
T 범주 | 종양 기준 |
TX | 원발성 종양을 평가할 수 없음 |
T1 | 췌장에 국한되고 크기가 2cm 이하 |
T2 | 췌장에 국한되고 크기가 2cm–4cm |
T3 | 췌장에 국한되고 > 4cm; 또는 십이지장 또는 담관을 침범 |
T4 | 인접 장기 또는 큰 혈관 벽 침범 |
국소 림프절 (N) | |
N 범주 | N 기준 |
NX | 국소 림프절을 평가할 수 없음 |
N0 | 국소 림프절 침범 없음 |
N1 | 국소 림프절 침범 |
원격 전이 (M) | |
M 범주 | M 기준 |
M0 | 원격 전이 없음 |
M1 | 원격 전이 |
M1a | 간에 국한된 전이 |
M1b | 적어도 하나의 간외 부위에 전이 |
M1c | 간 및 간외 전이 모두 존재 |
AJCC 예후 병기 그룹 | |
병기 | 기준 |
I | T1, N0, M0 |
II | T2 또는 T3, N0, M0 |
III | 모든 T, N1, M0; T4, N0, M0 |
IV | 모든 T, 모든 N, M1 |
7. 치료
신경내분비 종양의 적절한 치료법을 결정하는 데에는 종양의 위치, 침습성, 호르몬 분비, 전이 등 여러 요인이 고려된다. 치료는 질병을 완치하거나 증상을 완화하는 고식적 치료를 목표로 할 수 있다. 기능이 없는 저등급 신경내분비 종양은 경과를 관찰하는 경우도 있지만, 종양이 국소적으로 진행되었거나 전이되었더라도 천천히 성장하는 경우에는 즉각적인 수술보다 증상 완화 치료를 우선하기도 한다. 반면, 중간 등급 및 고등급 종양은 일반적으로 관찰보다는 다양한 방법으로 조기에 적극적으로 치료하는 것이 권장된다.[70]
지난 수십 년간 치료법이 발전하면서 치료 결과도 개선되고 있다.[89] 예를 들어, 카르시노이드 증후군이 있는 악성 카르시노이드 종양의 중앙값 생존율은 과거 2년에서 현재 8년 이상으로 향상되었다.[104]
주요 치료 방법으로는 종양을 직접 제거하는 수술, 고주파 열 치료술, 간 전이에 대한 간동맥 색전술 등이 있다. 절제가 어렵거나 재발, 전이된 경우에는 화학 요법, 표적 치료제, 소마토스타틴 유사체와 같은 약물 치료나 방사선 치료 등이 시행될 수 있다.
신경내분비 종양 관리에 대한 상세한 지침은 ESMO[71], NCCN[72], 영국의 전문가 패널[1] 등에서 제공하고 있다. NCI 역시 췌장의 섬세포 종양,[73] 위장관 카르시노이드,[74] 메르켈 세포 종양,[75] 갈색세포종/부신경절종에 대한 지침을 제공한다.[76] 그러나 아직 치료 효과를 예측할 수 있는 효과적인 예측 표지자 생체 지표는 부족한 실정이며, 신경내분비 종양의 분자적 및 유전체적 특성에 대한 최근 연구 결과들이 아직 명확한 치료 전략으로 이어지지는 못하고 있다.[77]
7. 1. 외과적 절제
기본적으로 절제가 가능하다면 수술을 통한 근치적 절제술을 시도한다. 소화관 원발 신경내분비 종양에서는 정형 림프절 곽청술을 동시에 시행한다.종양이 진행되어 전이되어 완치 목적의 수술이 불가능하더라도, 수술은 종종 증상 완화 및 수명 연장을 위해 시행될 수 있다.[70]
담낭 절제술은 장기간의 소마토스타틴 구조적 유사체 치료를 고려하는 경우 권장된다.[78]
7. 2. 약물 치료
절제가 불가능하거나 재발 또는 전이된 신경내분비 종양의 경우 약물 치료를 시행한다. 주요 약물로는 소마토스타틴 유사체, 표적 치료제, 세포 독성 화학 요법 약물, 인터페론 등이 있다.소마토스타틴 유사체분비성 종양에서 과도한 호르몬 분비로 인한 증상(예: 카르시노이드 증후군)을 완화하기 위해 사용된다. 소마토스타틴 유사체는 호르몬 방출을 차단하여 증상을 조절할 뿐만 아니라[79], 종양의 성장을 억제하는 효과도 기대할 수 있다.
- '''옥트레오티드''' (산도스타틴): PROMID 연구에서 전이성 중장 신경내분비 종양 환자의 종양 진행을 늦추는 효과를 보였는데, 위약 그룹의 평균 무진행 기간이 6개월인 데 비해 옥트레오티드 치료 그룹은 14.3개월로 나타났다.[80] 소화관 원발 신경내분비 종양 치료에 사용된다.[1]
- '''란레오티드''' (소마툴린): CLARINET 연구를 통해 위장관 및 췌장 신경내분비 종양(GEP-NETs)에서 항증식 효과가 입증되었다.[81] 이 연구에서 란레오티드는 위약 대비 질병 진행 또는 사망 위험을 53% 감소시켰으며 (96주차 무진행 생존율: 란레오티드 65% vs 위약 33%),[81] 이를 바탕으로 미국 FDA 승인을 받았다.[81] 소화관 및 췌장 원발 신경내분비 종양 치료에 사용된다.[1]
표적 치료제특정 분자 표적을 공격하여 암세포의 성장과 증식을 억제하는 약물이다. 주로 췌장 신경내분비 종양(PanNETs) 치료에 사용된다.
- '''에베롤리무스''' (아피니토): 절제 불가능하거나 전이된 췌장 신경내분비 종양 치료제로 FDA 승인을 받았다.[1] RADIANT-3 시험에서 췌장 신경내분비 종양 환자의 무진행 생존 기간을 유의하게 연장했다.[110] 이후 RADIANT-4 시험을 통해 진행성 비기능성 위장관 및 폐 신경내분비 종양에서도 효과를 입증하여 적응증이 확대되었다.[111][1]
- '''수니티닙''' (수텐트): 절제 불가능하거나 전이된 췌장 신경내분비 종양 치료제로 FDA 승인을 받았다.[1] A6181111 시험에서 위약 대비 무진행 생존 기간을 유의하게 연장하는 효과를 보였다.[1]
화학 요법 (세포 독성 약물)빠르게 분열하는 암세포를 직접 공격하는 전통적인 항암제이다. 신경내분비 종양은 종류에 따라 화학 요법에 대한 반응이 다르다.
- '''위장관 카르시노이드 종양''': 대부분 화학 요법에 잘 반응하지 않는다.[84] 단일 약제 반응률은 10~20% 수준이며, 여러 약물을 병용해도 반응률은 25~35% 정도로 제한적이다.[84]
- '''췌장 신경내분비 종양 (PanNETs)''': 위장관 카르시노이드 종양보다 화학 요법에 더 잘 반응하는 경향이 있다.
- 스트렙토조신 (STZ: 자노서) 기반 요법이 사용된다.[1][84] 독소루비신, 플루오로우라실(5-FU) 등과 병용하기도 한다.[84][1]
- 카페시타빈과 테모졸로미드 병용 요법도 시도되지만, 아직 보험 적용은 되지 않는다.[1]
- '''분화가 나쁜 신경내분비암 (PDNECs)''': 분화도가 좋은 종양과 달리 화학 요법에 비교적 잘 반응한다. 시스플라틴과 에토포시드 병용 요법이 주로 사용된다.[84][1] 특히 소마토스타틴 수용체 발현이 없는(SSRS 음성) 종양에서 반응률이 높게 나타난다 (70% 이상).[1]
인터페론면역 체계를 조절하여 항종양 효과를 유도하는 약물이다. GEP-NET 치료에 사용되기도 하지만[82], 그 효과는 다소 불확실하며 환자별로 용량 조절이 필요하다.[82] 단독으로 사용하기보다는 소마토스타틴 유사체 등 다른 약물과 함께 병용하는 경우가 많다.[83]
특정 호르몬의 분비 효과를 차단하는 다른 약물들도 증상 완화를 위해 사용될 수 있다.[84]
7. 3. 방사선 치료
펩타이드 수용체 방사성핵종 치료법(PRRT)은 방사성 동위원소 치료(RIT)의 한 종류이다.[7] 이 치료법은 펩타이드나 호르몬을 방사성 핵종 또는 방사성 리간드에 접합하여 정맥으로 투여하는 방식이다. 펩타이드나 신경아민 호르몬은 소마토스타틴 수용체 영상을 통해 추적자 용량이 잘 흡수되는 것을 보여준다. 이 방사선 치료는 전신에 작용하며, 소마토스타틴 수용체가 양성인 질환에 효과가 있다.[85] 펩타이드 수용체에는 루테튬-177(177Lu), 이트륨-90(90Y), 인듐-111(111In)이나 알파 방출기 같은 다양한 방사성 동위원소를 결합시킬 수 있다.[86]이 치료법은 소마토스타틴이 세포 표면에 많이 발현되는 종양에 매우 효과적이다. 방사선이 종양 부위에 흡수되거나 소변으로 배출되기 때문에 부작용이 최소화된, 매우 표적화된 치료법이다. 방사성 표지된 호르몬은 종양 세포 안으로 들어가며, 부착된 방사선은 해당 세포와 주변 세포를 손상시킨다. 모든 세포가 즉시 사멸하는 것은 아니며, 세포 사멸 효과는 최대 2년까지 지속될 수 있다.
PRRT는 초기에 낮은 등급의 신경내분비 종양(NET) 치료에 사용되었다. 소마토스타틴 수용체(SSTR) 영상에서 방사성 물질 흡수가 높게 나타나 치료 효과가 기대되는 경우에는, 등급 2 및 3과 같이 더 공격적인 신경내분비 종양에도 매우 유용하게 사용될 수 있다.[87][88]
7. 4. 간동맥 색전술 (HAE)
간으로 신경내분비 종양이 전이된 경우, 종양 세포는 주로 간동맥에서 영양분을 공급받는다. 반면, 간의 정상 세포는 문맥에서 영양분과 산소의 약 70~80%를 공급받기 때문에, 간 동맥을 차단해도 정상 세포는 생존할 수 있다. 이러한 차이를 이용하여 여러 종류의 간 동맥 치료법을 시행할 수 있다.[89][90]간 동맥 색전술(HAE, Hepatic Artery Embolization)은 간동맥으로의 혈류를 인위적으로 막아 종양으로 가는 영양 공급을 차단하는 치료법이다. 이 방법을 통해 80% 이상의 환자에서 종양 크기를 현저하게 줄일 수 있다.[47] 이는 간 전이에 대한 국소 치료법 중 하나로 사용된다.
HAE 외에도 간 동맥을 이용한 다른 치료법들이 있다.
- 간 동맥 화학 요법은 화학 요법 약물을 간 동맥에 직접 투여하는 방식이다. 때로는 수 시간 또는 며칠 동안 지속적으로 주입하기도 한다. 전신 화학 요법에 비해 간 병변에 더 높은 농도의 약물을 전달할 수 있다는 장점이 있다.[90]
- 간 동맥 화학 색전술(HACE, Hepatic Artery Chemoembolization)은 때때로 TACE라고도 불리며, 간 동맥 색전술(HAE)과 간 동맥 화학 요법을 결합한 치료법이다. 항암제가 포함된 작은 구슬을 간 동맥에 주입하면, 이 구슬들이 종양 주변의 미세 혈관에 자리 잡아 혈류를 차단하는 동시에 국소적으로 항암제를 방출하여 치료 효과를 높인다.
- 선택적 내부 방사선 치료법(SIRT, Selective Internal Radiation Therapy)[91]은 방사선을 방출하는 미세 구슬을 간 동맥에 주입하는 방식이다. 이 구슬들은 HAE나 HACE처럼 종양 주변 혈관에 자리 잡는다. 이 치료법은 종양이 특정 수용체(펩타이드 수용체)를 많이 가지고 있지 않아도 시행할 수 있으며, 방사선을 종양에 집중시키고 정상 간 조직에 미치는 영향을 최소화한다.[93] SIRT는 대장암 등의 간 전이에 대해 미국 식품의약국(FDA)의 승인을 받았으며, 신경내분비 종양의 간 전이에 대한 효과도 연구 중이다.[91]
7. 5. 기타 치료
AdVince는 유전자 변형된 종양 용해 아데노바이러스를 사용하는 유전자 치료의 한 종류이다. 크라우드 펀딩 캠페인 iCancer의 지원을 받아 2016년에 신경내분비 종양(NET)을 대상으로 하는 1상 임상 시험에 사용되었다.[96]신경내분비 종양에 대해 보다 맞춤형 치료법을 개발하려는 추가적인 노력이 진행 중이다. 예를 들어, 약물 테스트 플랫폼과 원래 신생물의 관련 특징을 모방하는 환자 유래 ''생체 외'' 세포 배양을 결합하는 방식 등이 연구되고 있다.[98][99]
8. 역학
임상적으로 의미 있는 신경내분비 종양의 연간 발생률은 추정치에 차이가 있지만, 대략 10만 명당 2.5~5명이다.[100] 이 중 2/3는 카르시노이드 종양이고 1/3은 기타 신경내분비 종양(NET)이다.
유병률은 10만 명당 35명으로 추정되지만,[100] 임상적으로 증상이 없는 종양을 포함하면 실제 유병률은 훨씬 더 높을 수 있다. 실제로 관련 없는 원인으로 사망한 사람들의 췌장을 부검한 연구에서는 작고 증상이 없는 NET의 발생률이 매우 높은 것으로 나타났다. 췌장의 무작위 3개 단면을 일상적으로 현미경 검사했을 때 1.6%에서 NET이 발견되었고, 여러 단면을 검사했을 때는 10%에서 NET이 확인되었다.[101] 내시경 초음파 검사와 같이 진단 영상 기술의 민감도가 높아짐에 따라, 임상적으로 중요하지 않은 매우 작은 NET이 우연히 발견되는 경우가 늘고 있다. 이러한 종양은 증상과 관련이 없기 때문에 수술적 절제가 필요하지 않을 수도 있다.
참조
[1]
논문
Guidelines for the management of gastroenteropancreatic neuroendocrine (including carcinoid) tumours
2005-06
[2]
논문
Hindered submicron mobility and long-term storage of presynaptic dense-core granules revealed by single-particle tracking
2012-09
[3]
논문
Nothing But NET: A Review of Neuroendocrine Tumors and Carcinomas
2017-12
[4]
논문
Goblet cell carcinoid of the appendix: a specific type of carcinoma
2007-12
[5]
논문
Overview of the 2022 WHO Classification of Neuroendocrine Neoplasms
2022-03
[6]
논문
Microtubule-associated protein-2: a new sensitive and specific marker for pulmonary carcinoid tumor and small cell carcinoma
2001-09
[7]
논문
Imaging of neuroendocrine tumors
2006-07
[8]
논문
Carcinoids and their variant endocrinomas. An analysis of 11842 reported cases
2003-12
[9]
논문
Evaluation of 342 cases of mediastinal/thymic carcinoids collected from literature: a comparative study between typical carcinoids and atypical varieties
1999-10
[10]
논문
Neuroendocrine bronchial and thymic tumors: ESMO clinical recommendation for diagnosis, treatment and follow-up
2008-05
[11]
논문
The 2004 World Health Organization classification of lung tumors
2005-04
[12]
논문
Bronchopulmonary neuroendocrine tumors
2008-07
[13]
논문
Large cell carcinoma of the lung with neuroendocrine differentiation. A comparison with large cell "undifferentiated" pulmonary tumors
1992-06
[14]
논문
Neuroendocrine tumors of the gastro-entero-pancreatic system
2008-09
[15]
논문
Gastroenteropancreatic neuroendocrine tumours
2008-01
[16]
논문
Gastrointestinal neuroendocrine tumors: pancreatic endocrine tumors
2008-11
[17]
논문
Appendiceal neuroendocrine tumors: Recent insights and clinical implications
2010-04
[18]
논문
Pathologic research update of colorectal neuroendocrine tumors
2010-04
[19]
논문
Treatment of colorectal carcinoids: A new paradigm
2010-05
[20]
논문
Primary hepatic endocrinomas (carcinoids and variant neoplasms). A statistical evaluation of 126 reported cases
2002-12
[21]
논문
Primary hepatic carcinoid tumours
2004
[22]
논문
Hepatic gastrinoma
1993-09
[23]
논문
Primary endocrinomas (carcinoids and variant neoplasms) of the gallbladder. A statistical evaluation of 138 reported cases
2003-03
[24]
논문
Gut-endocrinomas (carcinoids and related endocrine variants) of the breast: an analysis of 310 reported cases
2001
[25]
논문
Carcinoid tumors of the urinary tract and prostate
2006-11
[26]
논문
"[Non-urothelial tumors of the urinary tract]"
1993
[27]
논문
Gut-endocrinomas (carcinoids and related endocrine variants) of the uterine cervix: an analysis of 205 reported cases
2001-09
[28]
논문
Neuroendocrine differentiation in castration resistant prostate cancer. Nuclear medicine radiopharmaceuticals and imaging techniques: A narrative review
2019-06
[29]
논문
Cellular plasticity and the neuroendocrine phenotype in prostate cancer
2018-05
[30]
논문
Inherited pancreatic endocrine tumor syndromes: advances in molecular pathogenesis, diagnosis, management, and controversies
2008-10
[31]
논문
Neurofibromatosis: clinical presentations and anaesthetic implications
2001-04
[32]
논문
Endocrine tumours in neurofibromatosis type 1, tuberous sclerosis and related syndromes
2010-06
[33]
논문
Are neuroendocrine tumours a feature of tuberous sclerosis? A systematic review
2009-03
[34]
웹사이트
Carney Complex, type 1; CNC1
http://www.omim.org/[...]
[35]
웹사이트
Carney Complex, type 2; CNC2
http://www.omim.org/[...]
[36]
서적
WHO Classification of Tumours of the Digestive System
International Agency for Research on Cancer
[37]
논문
The high-grade (WHO G3) pancreatic neuroendocrine tumor category is morphologically and biologically heterogenous and includes both well differentiated and poorly differentiated neoplasms
2015-05
[38]
서적
AJCC Cancer Staging Manual
Springer Science+Business Media
[39]
서적
AJCC Cancer Staging Manual
Springer Science+Business Media
[40]
서적
AJCC Cancer Staging Manual
Springer Science+Business Media
[41]
웹사이트
Pathology, classification, and grading of neuroendocrine neoplasms arising in the digestive system
https://www.uptodate[...]
2019-10-29
[42]
서적
AJCC Cancer Staging Manual
Springer Science+Business Media
[43]
서적
AJCC Cancer Staging Manual
Springer Science+Business Media
[44]
서적
AJCC Cancer Staging Manual
Springer Science+Business Media
[45]
논문
Clinical pathology of endocrine tumors of the pancreas. Analysis of autopsy cases
1991-07
[46]
웹사이트
Carcinoid Tumor Overview.
http://www.healthcom[...]
[47]
웹사이트
Carcinoid Tumors and the Carcinoid Syndrome: What's New in the Therapeutic Pipeline.
http://www.carcinoid[...]
The Carcinoid Cancer Foundation
2002
[48]
웹사이트
Cushing's Syndrome
https://www.lecturio[...]
2021-09-28
[49]
논문
Neuroendocrine pancreatic tumors: guidelines for management and update
2012-03
[50]
논문
Wildlife biology. A devil of a disease
2005-02
[51]
뉴스
Tasmanian devil facial cancer origins 'identified'
http://news.bbc.co.u[...]
BBC
2010-01-01
[52]
뉴스
Decoding the Tasmanian Devil's Deadly Cancer
http://www.time.com/[...]
Time
2010-01-01
[53]
논문
Pancreatic Neuroendocrine Tumors (Islet Cell Tumors) Treatment (PDQ®): Health Professional Version
https://www.ncbi.nlm[...]
National Cancer Institute
2022-08
[54]
논문
The neuroendocrine concept today
1994-09
[55]
웹사이트
investigations – General Practice Notebook
http://www.gpnoteboo[...]
2017-02-23
[56]
논문
Neuroendocrine tumors of the gastrointestinal tract: recent advances in molecular genetics, diagnosis, and treatment
2005-07
[57]
논문
Imaging of gastroenteropancreatic neuroendocrine tumors
2011-01
[58]
논문
Neuroendocrine tumours: the role of imaging for diagnosis and therapy
2014-02
[59]
논문
High management impact of Ga-68 DOTATATE (GaTate) PET/CT for imaging neuroendocrine and other somatostatin expressing tumours
2012-02
[60]
논문
Management of Small Bowel Neuroendocrine Tumors
2018-08
[61]
논문
Changing paradigms with molecular imaging of neuroendocrine tumors
http://www.discovery[...]
2015-11-08
[62]
논문
Advances in the Diagnosis and Management of Well-Differentiated Neuroendocrine Neoplasms
2020-04
[63]
논문
Direct comparison of (68)Ga-DOTA-TOC and (18)F-FDG PET/CT in the follow-up of patients with neuroendocrine tumour treated with the first full peptide receptor radionuclide therapy cycle
2016-08
[64]
논문
The development and characterization of a human midgut carcinoid cell line
2007-08
[65]
논문
Biomarkers in neuroendocrine tumors
2010-01
[66]
논문
The biological characterization of neuroendocrine tumors: the role of neuroendocrine markers
2008-03
[67]
논문
Insulinoma-associated protein 1 (INSM1) is a sensitive and highly specific marker of neuroendocrine differentiation in primary lung neoplasms: an immunohistochemical study of 345 cases, including 292 whole-tissue sections
2019-01
[68]
뉴스
Definition of Mesentery
https://www.medicine[...]
2018-04-21
[69]
웹사이트
Carcinoid Tumor
http://emedicine.med[...]
WebMD LLC
2014-04-01
[70]
논문
Enteroendocrine tumors other than carcinoid: a review of clinically significant advances
2005-05
[71]
논문
Neuroendocrine gastroenteropancreatic tumours: ESMO Clinical Practice Guidelines for diagnosis, treatment and follow-up
2010-05
[72]
논문
NCCN Clinical Practice Guidelines in Oncology: neuroendocrine tumors
2009-07
[73]
웹사이트
Islet Cell Tumors (Endocrine Pancreas)
http://www.cancer.go[...]
[74]
웹사이트
Gastrointestinal Carcinoid Tumors Treatment
http://www.cancer.go[...]
[75]
웹사이트
Merkel cell tumors
http://www.cancer.go[...]
2006-02-21
[76]
웹사이트
Pheochromocytoma and Paraganglioma
http://www.cancer.go[...]
[77]
논문
Treatment of advanced gastroenteropancreatic neuroendocrine neoplasia, are we on the way to personalised medicine?
2021-09
[78]
웹사이트
Neuroendocrine tumors, NCCN Guidelines Version 1.2015
http://www.nccn.org/[...]
National Comprehensive Cancer Network, Inc.
2014-11-11
[79]
논문
Consensus report on the use of somatostatin analogs for the management of neuroendocrine tumors of the gastroenteropancreatic system
2004-06
[80]
논문
Placebo-controlled, double-blind, prospective, randomized study on the effect of octreotide LAR in the control of tumor growth in patients with metastatic neuroendocrine midgut tumors: a report from the PROMID Study Group
2009-10
[81]
논문
Lanreotide in metastatic enteropancreatic neuroendocrine tumors
2014-07
[82]
간행물
Neuroendocrine Gastroenteropancreatic Tumours: Current Views on Diagnosis and Treatment
Business Briefing. European Oncology Review
2005
[83]
논문
Progress in the treatment of neuroendocrine tumors
2009-05
[84]
서적
Cancer Management: A Multidisciplinary Approach
UBM Medica
2011-03
[85]
논문
Phase 3 Trial of 177Lu-Dotatate for Midgut Neuroendocrine Tumors
2017-01
[86]
논문
²¹³Bi-DOTATOC receptor-targeted alpha-radionuclide therapy induces remission in neuroendocrine tumours refractory to beta radiation: a first-in-human experience
2014-11
[87]
논문
Favourable outcomes of (177)Lu-octreotate peptide receptor chemoradionuclide therapy in patients with FDG-avid neuroendocrine tumours
2015-02
[88]
논문
Modifying the Poor Prognosis Associated with 18F-FDG-Avid NET with Peptide Receptor Chemo-Radionuclide Therapy (PRCRT)
2015-06
[89]
학술발표
The role of surgery and chemoembolization in the management of carcinoid.
http://www.carcinoid[...]
2003-10
[90]
뉴스
Arterial Chemotherapy Infusion of the Liver (and) Chemoembolization of the Liver (TACE)
http://www.medicinen[...]
2015-11-08
[91]
논문
Selective Internal Radiation Therapy (SIRT) for liver metastases secondary to colorectal adenocarcinoma
[92]
논문
Yttrium-90 labelled resin microspheres for treatment of primary and secondary malignant liver tumors
2009-06
[93]
논문
Yttrium-90 microspheres: radiation therapy for unresectable liver cancer
2002-09
[94]
웹사이트
A plutocratic proposal
http://mosaicscience[...]
The Wellcome Trust
2014-10-14
[95]
웹사이트
iCancer web site
http://icancer.org.u[...]
[96]
웹사이트
Can crowdfunding really cure cancer? Alexander Masters investigates a pioneering new project
https://www.telegrap[...]
The Telegraph
2016-07-02
[97]
논문
Models of Gastroenteropancreatic Neuroendocrine Neoplasms: Current Status and Future Directions
2020-07-02
[98]
논문
Patient derived tumoroids of high grade neuroendocrine neoplasms for more personalized therapies
2024-03
[99]
논문
Three-Dimensional Primary Cell Culture: A Novel Preclinical Model for Pancreatic Neuroendocrine Tumors
2020-04-03
[100]
논문
Current knowledge on diagnosis and staging of neuroendocrine tumors
2011-03
[101]
논문
Clinical pathology of endocrine tumors of the pancreas. Analysis of autopsy cases
1991-07
[102]
논문
Siegfried Oberndorfer: origins and perspectives of carcinoid tumors
2004-12
[103]
서적
Gastrointestinal and Liver Tumors
Springer
[104]
논문
Carcinoid Tumors: Current Concepts in Diagnosis and Treatment
[105]
논문
The pathologic classification of neuroendocrine tumors: a review of nomenclature, grading, and staging systems
2010-08
[106]
문서
詳細は免疫組織化学を参照の事。
[107]
서적
図解入門よくわかる病理診断学の基本としくみ
秀和システム
2016-05-25
[108]
문서
[109]
문서
[110]
논문
Everolimus for advanced pancreatic neuroendocrine tumors
https://www.ncbi.nlm[...]
2011-02-10
[111]
논문
Everolimus for the treatment of advanced, non-functional neuroendocrine tumours of the lung or gastrointestinal tract (RADIANT-4): a randomised, placebo-controlled, phase 3 study
https://www.ncbi.nlm[...]
2016-03-05
[112]
논문
Siegfried oberndorfer: Origins and perspectives of carcinoid tumors
https://archive.org/[...]
[113]
서적
Gastrointestinal and Liver Tumors
Springer
본 사이트는 AI가 위키백과와 뉴스 기사,정부 간행물,학술 논문등을 바탕으로 정보를 가공하여 제공하는 백과사전형 서비스입니다.
모든 문서는 AI에 의해 자동 생성되며, CC BY-SA 4.0 라이선스에 따라 이용할 수 있습니다.
하지만, 위키백과나 뉴스 기사 자체에 오류, 부정확한 정보, 또는 가짜 뉴스가 포함될 수 있으며, AI는 이러한 내용을 완벽하게 걸러내지 못할 수 있습니다.
따라서 제공되는 정보에 일부 오류나 편향이 있을 수 있으므로, 중요한 정보는 반드시 다른 출처를 통해 교차 검증하시기 바랍니다.
문의하기 : help@durumis.com